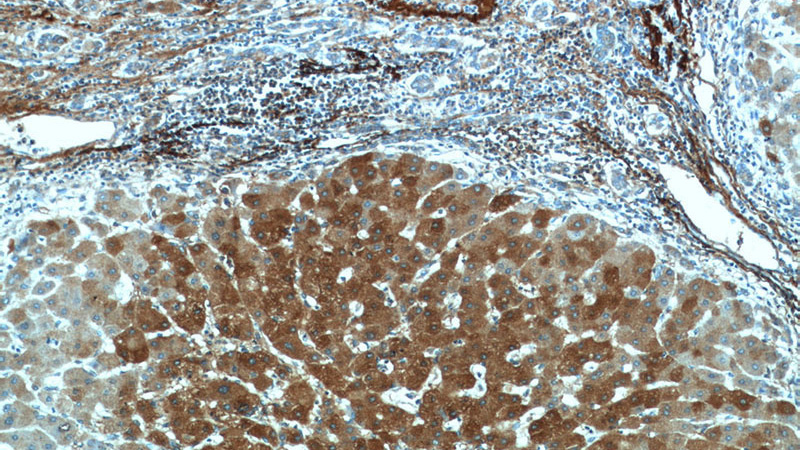
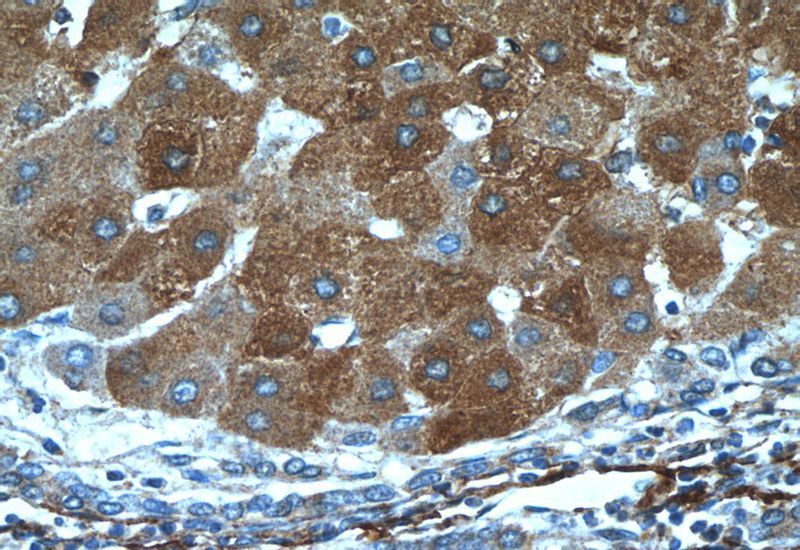

-
Product Name
Vitronectin antibody
- Documents
-
Description
Vitronectin Rabbit Polyclonal antibody. Positive IF detected in NIH/3T3 cells. Positive IHC detected in human hepat℃irrhosis tissue, human liver tissue, human testis tissue. Positive WB detected in human serum tissue, human testis tissue, NIH/3T3 cells. Observed molecular weight by Western-blot: 75 kDa
-
Tested applications
ELISA, WB, IHC, IF
-
Species reactivity
Human,Mouse,Rat; other species not tested.
-
Alternative names
S protein antibody; Serum spreading factor antibody; V75 antibody; vitronectin antibody; VNT antibody; VTN antibody
-
Isotype
Rabbit IgG
-
Preparation
This antibody was obtained by immunization of Vitronectin recombinant protein (Accession Number: NM_000638). Purification method: Antigen affinity purified.
-
Clonality
Polyclonal
-
Formulation
PBS with 0.02% sodium azide and 50% glycerol pH 7.3.
-
Storage instructions
Store at -20℃. DO NOT ALIQUOT
-
Applications
Recommended Dilution:
WB: 1:1000-1:10000
IHC: 1:20-1:200
IF: 1:50-1:500
-
Validations

human serum tissue were subjected to SDS PAGE followed by western blot with Catalog No:116760(VTN antibody) at dilution of 1:1000
Immunohistochemistry of paraffin-embedded human hepatocirrhosis tissue slide using Catalog No:116760(VTN Antibody) at dilution of 1:50 (under 10x lens)
Immunohistochemistry of paraffin-embedded human hepatocirrhosis tissue slide using Catalog No:116760(VTN Antibody) at dilution of 1:50 (under 40x lens)

Immunofluorescent analysis of (-20oc Ethanol) fixed NIH/3T3 cells using Catalog No:116760(VTN Antibody) at dilution of 1:50 and Alexa Fluor 488-congugated AffiniPure Goat Anti-Rabbit IgG(H+L)
-
Background
Vitronectin is a 75-kDa glycoprotein present in blood and in the extracellular matrix (PMID: 10399314). Vitronectin is a multifunctional glycoprotein that mediates cell-to-substrate adhesion, inhibits the cytolytic action of the terminal complement cascade in vitro and binds to several serine protease inhibitors of the serpin family (PMID: 1372588).
-
References
- Zhang H, Wu P, Chen F. SILAC-based quantitative proteomic analysis of secretome between activated and reverted hepatic stellate cells. Proteomics. 14(17-18):1977-86. 2014.
- Liu Z, Gao Y, Hao F. Secretomes are a potential source of molecular targets for cancer therapies and indicate that APOE is a candidate biomarker for lung adenocarcinoma metastasis. Molecular biology reports. 41(11):7507-23. 2014.
Related Products / Services
Please note: All products are "FOR RESEARCH USE ONLY AND ARE NOT INTENDED FOR DIAGNOSTIC OR THERAPEUTIC USE"
